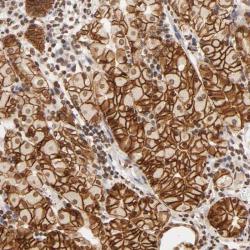

Antibody data
- Antibody Data
- Antigen structure
- References [1]
- Comments [0]
- Validations
- Western blot [1]
- Immunohistochemistry [1]
Submit
Validation data
Reference
Comment
Report error
- Product number
- sc-25599 - Provider product page

- Provider
- Santa Cruz Biotechnology
- Proper citation
- Santa Cruz Biotechnology Cat#sc-25599, RRID:AB_2066539
- Product name
- Anti-CA9
- Antibody type
- Polyclonal
- Antigen
- Recombinant full-length protein
- Reactivity
- Human
- Host
- Rabbit
Submitted references Human monoclonal antibodies targeting carbonic anhydrase IX for the molecular imaging of hypoxic regions in solid tumours.
Ahlskog JK, Schliemann C, MÃ¥rlind J, Qureshi U, Ammar A, Pedley RB, Neri D
British journal of cancer 2009 Aug 18;101(4):645-57
British journal of cancer 2009 Aug 18;101(4):645-57
No comments: Submit comment
Supportive validation
- Submitted by
- per
- Main image

- Experimental details
- Western blot analysis of antibody specificity using a routine panel composed of IgG/HSA-depleted human plasma and protein lysates from selected human tissues and cell lines.
- Validation comment
- No bands detected.
- Primary Ab dilution
- 1:500
- Secondary Ab dilution
- 1:3000
- Lane 1
- Marker [kDa]: 230, 110, 82, 49.3, 32.2, 25.5, 17.6
- Lane 2
- RT-4
- Lane 3
- U-251MG sp
- Lane 4
- Human Plasma
- Lane 5
- Liver
- Lane 6
- Tonsil
- Theoretical target weight
- [kDa] 50
Supportive validation
- Submitted by
- per
- Main image
- Experimental details
- Immunohistochemical staining of human stomach shows distinct membranous and nuclear positivity in glandular cells.
- Validation comment
- Staining pattern consistent with experimental and/or bioinformatic data.